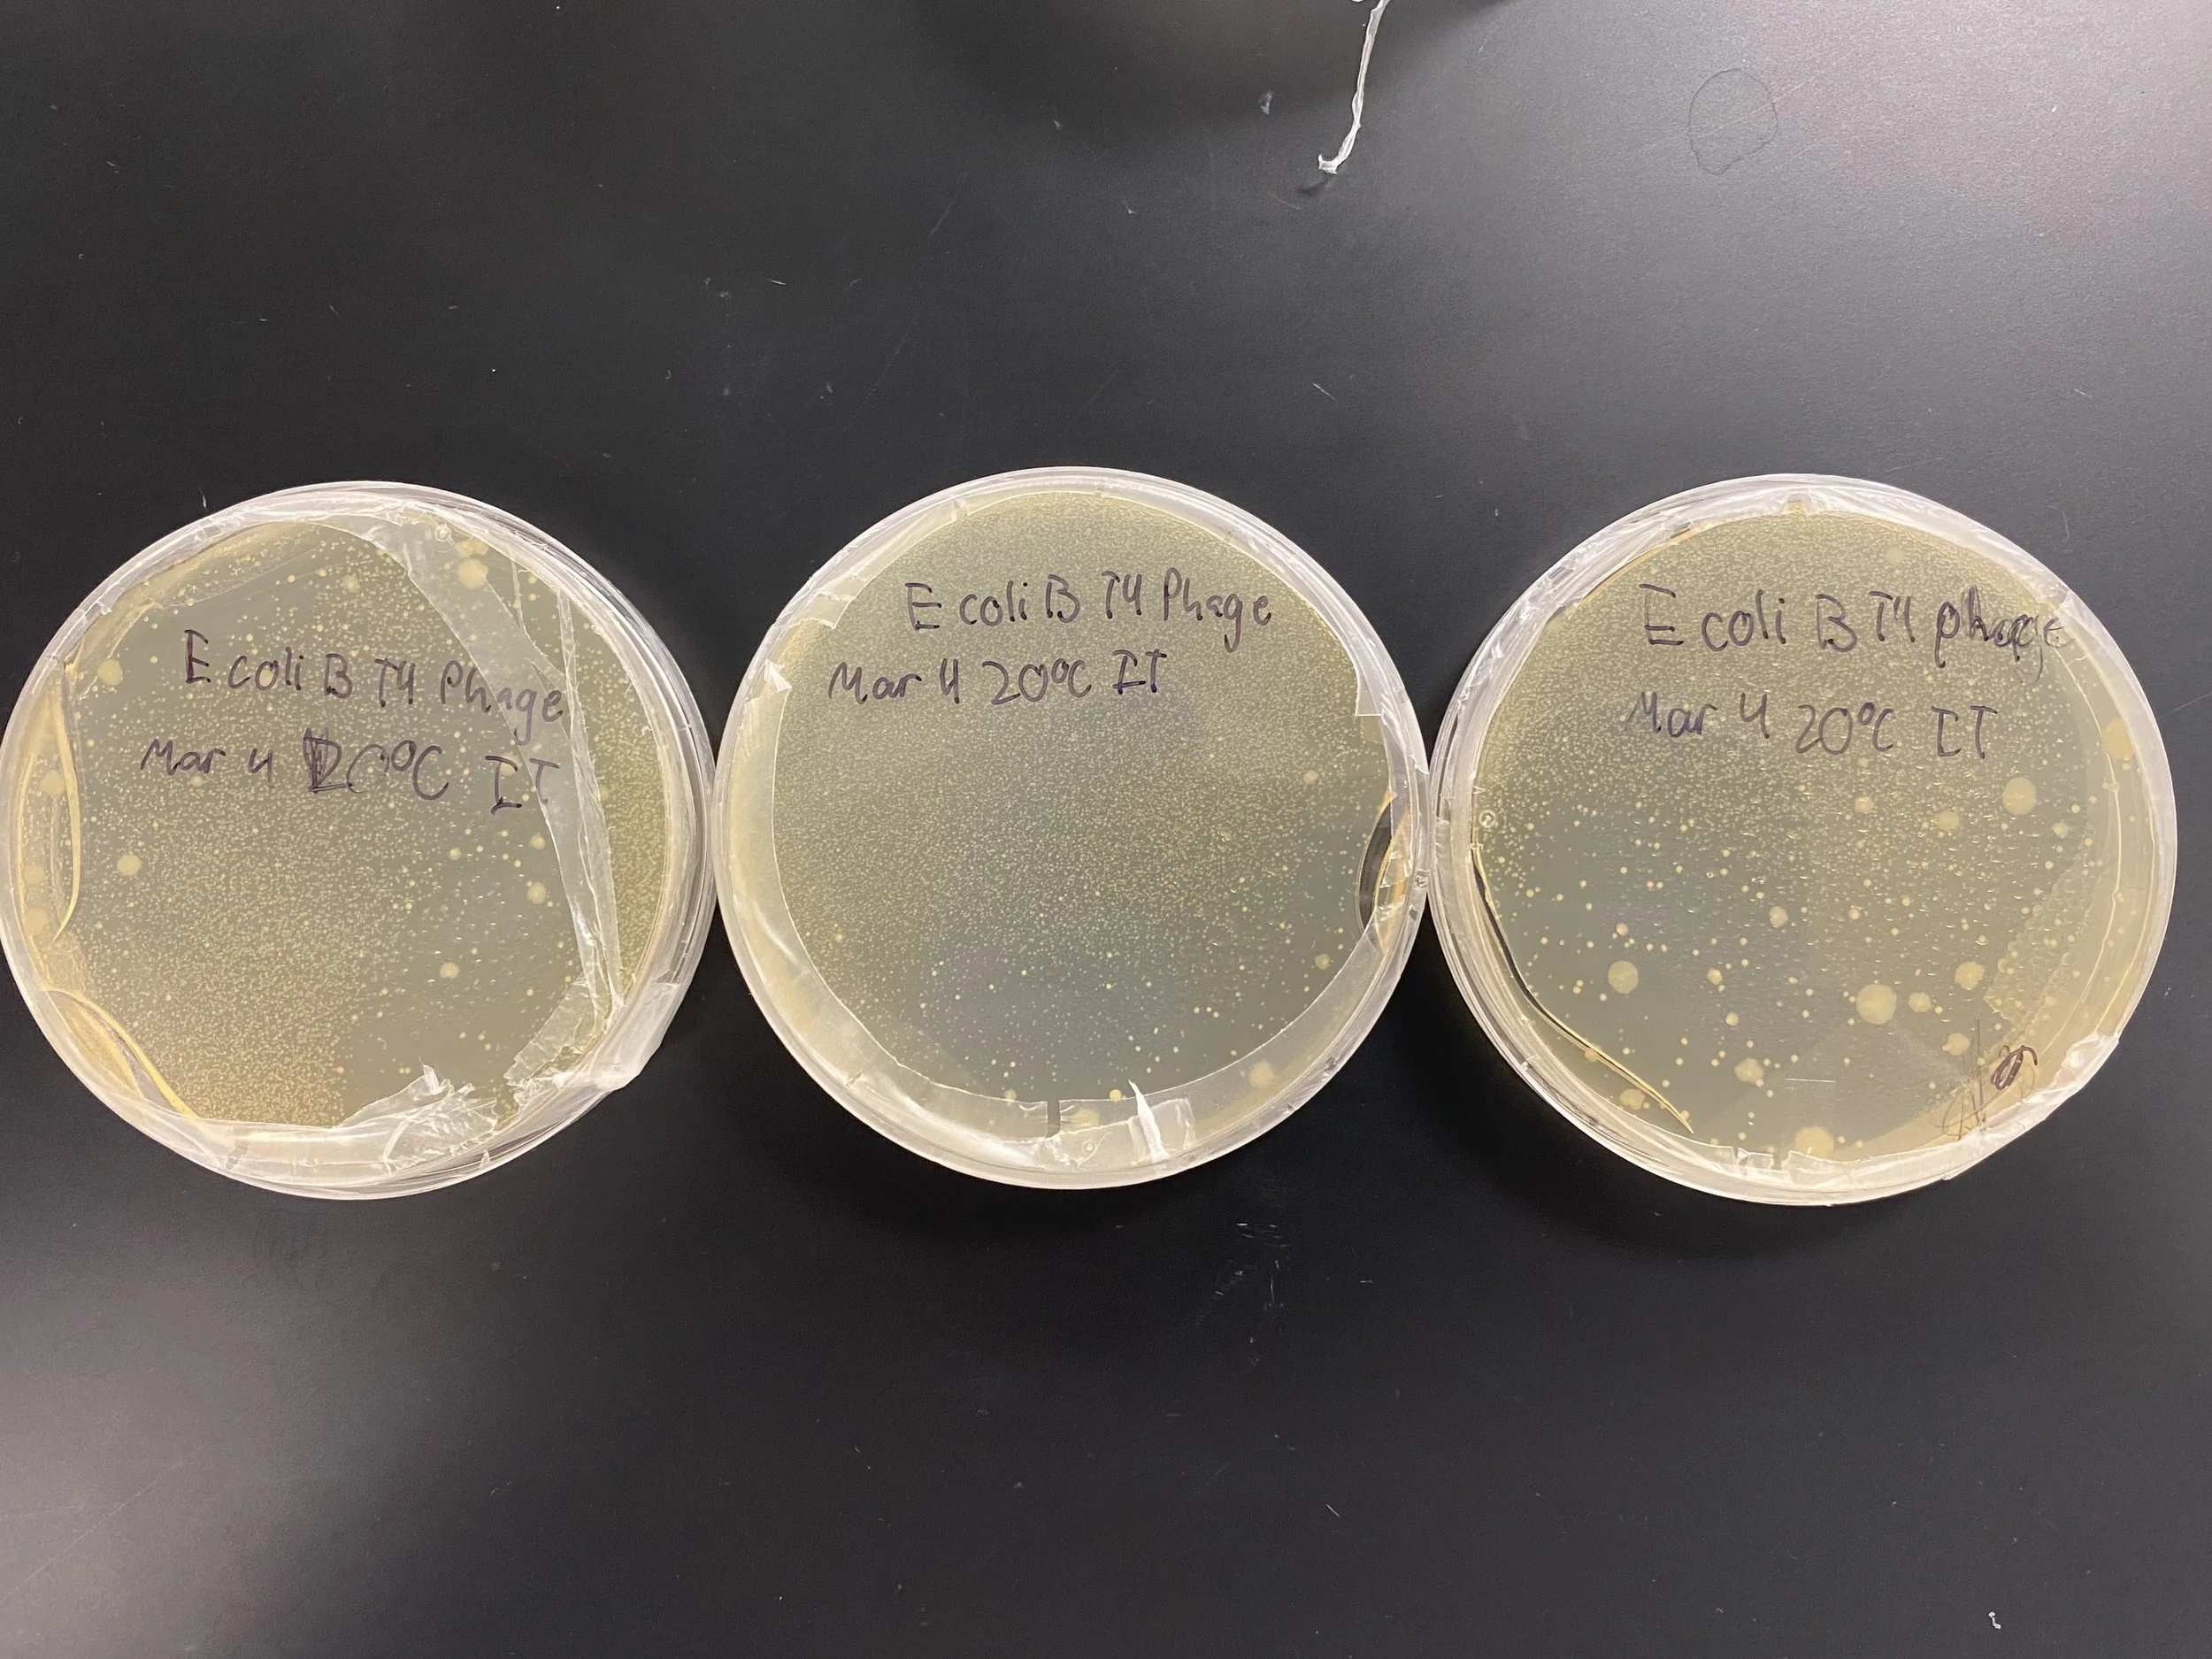
IMG_1239.jpeg

I’m Isavella, and I’m going to make a dent in the universe.

Experience:
Co-conducted my own phage stability lab at Mount Royal University
Co-founder at ClotGuard, an autonomous hemostasis solution
Worked alongside IKEA and XPRIZE and was selected as the top project for both companies globally
Quarterly Newsletter
Featured Work

An overview of what we built for TKS session 19’s Cerebras challenge sprint!